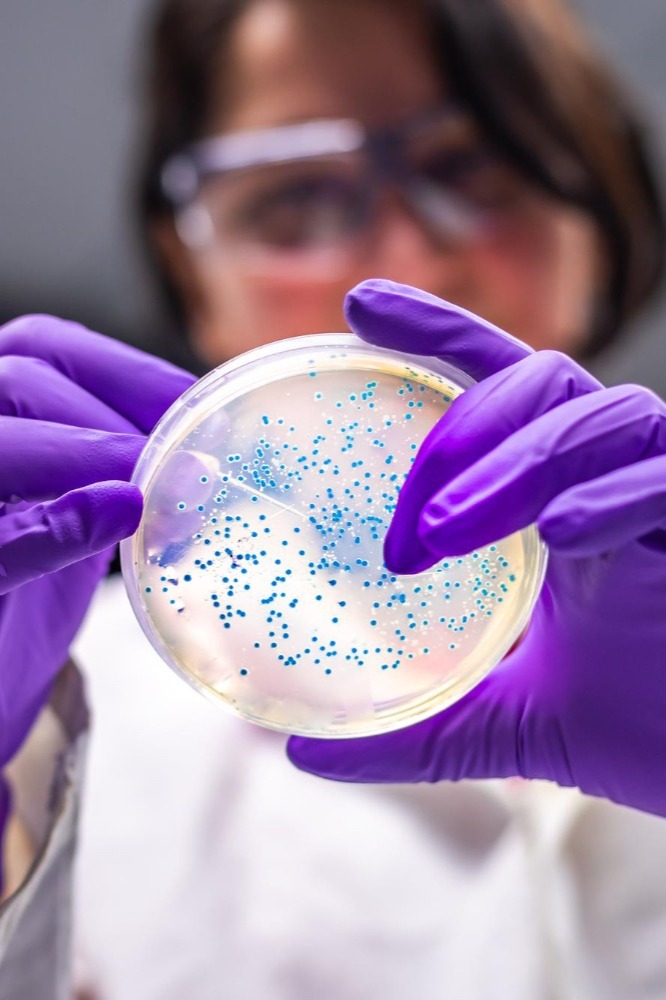

Activos Vegetales y Biotecnológicos: ¿Son la mejor alternativa a los sintéticos?
Hoy en día, la cosmética está viviendo una auténtica revolución verde y tecnológica. Cada vez más marcas buscan sustituir activos convencionales por ingredientes de origen vegetal o producidos por biotecnología, no solo por marketing, sino por sostenibilidad y una eficacia sorprendente.
Pero, como formuladores o amantes de la cosmética, la gran pregunta es: ¿funcionan igual de bien que los ingredientes de siempre? Esto no es una batalla de "natural vs. sintético", sino de entender qué herramienta es la mejor para cada trabajo, dependiendo de la necesidad de la piel, tu público y la filosofía de tu marca.
Por ello, hoy vamos a contarte un poco más sobre estas increíbles alternativas
Los Activos Vegetales: El poder de la naturaleza
Son los más populares. Se obtienen de extractos, aceites o fracciones purificadas de plantas y nos regalan un cóctel de compuestos que trabajan en sinergia.
Ejemplos que te encantarán:
✓ Vit-A-Like: La alternativa vegetal al retinol, ¡con resultados visibles y sin irritación!
✓ Betapur: Extraído del Boldo, un campeón anti-acné y antiinflamatorio.
✓ Fitoceramidas: Derivadas del arroz o trigo, son perfectas para reconstruir la barrera de la piel.
✓ Aquabio: Un activo inteligente que le enseña a tu piel a hidratarse mejor por sí misma.
Sabemos que procesar tanta información puede ser un lío. Por eso, en Lúdika te preparamos esta tabla comparativa para que veas de un vistazo las ventajas y limitaciones de cada grupo:

Entonces, volvemos a la gran pregunta: ¿funcionan igual o mejor?
La respuesta es: depende del activo, ¡pero muchos de ellos son increíbles! No se trata de elegir solo un bando, sino de saber combinar.
Por ejemplo, un sérum puede ser una obra maestra con péptidos (biotecnológicos), extractos antioxidantes (vegetales) y un conservador bien probado (sintético).
✓ Alternativas como Vit-A-Like han demostrado en estudios que pueden ofrecer resultados cara a cara con el retinol en la mejora de arrugas, pero sin la irritación.
✓ Los activos biotecnológicos a menudo son incluso más eficaces y estables que sus contrapartes, ya que se producen en condiciones perfectas.
Las alternativas vegetales y biotecnológicas no solo son una tendencia, son una oportunidad para crear cosmética más sostenible, innovadora y amable con la piel.
La clave del éxito para ti como creador:
1.- Conoce la concentración de uso que tiene estudios detrás.
2.- Verifica siempre la estabilidad en tu fórmula (pH, temperatura).
3.- Elige proveedores que te den ingredientes certificados y con fichas técnicas claras.
Así, crearás productos que no solo suenan bien en la etiqueta, sino que realmente cumplen lo que prometen.
Ahora que conoces un poco más... ¿Te animas a probarlas? Comienza con alguno de los activos que tenemos en Lúdika y cuéntanos tu experiencia. ¡Nos encantará saber de tus innovaciones!







